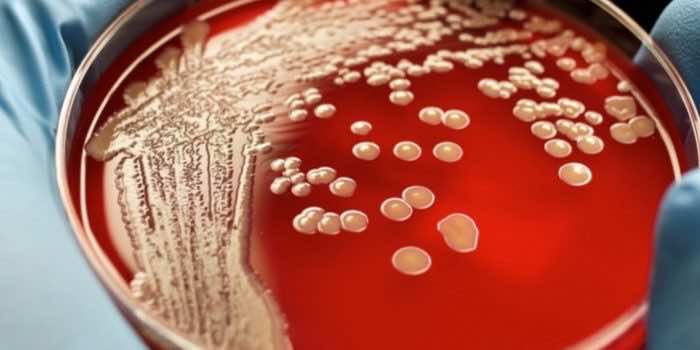

科学家们已经发现了一种新的细菌,Thiomargarita华丽号50倍比之前所知最大的细菌。这是首次发现在瓜德罗普岛红树林沼泽,小安的列斯群岛。
我们报告一个新物种形成的一个巨大的细菌…丝到20000微米长,“海洋微生物学家让-玛丽•Volland周二在新闻发布会上告诉记者。“他们今天到目前为止已知最大的细菌。一个细胞的平均时间大约是1厘米,”他说。t .华丽号的大小和形状是一个睫毛”不过是一个细菌细胞。”
研究人员一直在问解剖问题其他类型的“巨型”细菌。事实证明,t .华丽号可以帮助。在相关的文章同时发表的新研究中,细胞生物学家佩特拉安妮·莱文解释说,“[f]或大型细胞,分子扩散的可能是一个主要的挑战。“真核细胞细胞器速度重要任务发送消息和移动材料,但细菌没有这些工具。她写道,这一发现有助于解决哪些因素限制细胞大小的难题。”
生物研究表明,t .华丽号已经开发了一些不寻常的解剖学,包括一个独特的和前所未有的细胞器。”而不是自己在细胞质DNA自由浮动,这些巨型细胞内DNA小,膜结合隔间,“Volland说。”这些隔间代表一种新的细菌生物,我们叫“pepin,”这意味着,在法国,小种子在水果,”他说。

“直到现在,里面的包装细胞的DNA膜结合细胞器被认为是严格限制真核细胞,这是生物的积木等人类,其他动物或植物,“Volland说。“T。因此,华丽号是一个迷人的例子的细菌进化的更高层次的复杂性。”
t .华丽号并不是对人类有害。